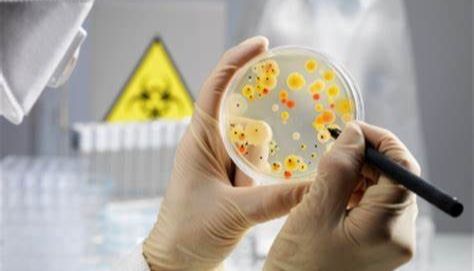
微生物培养基种类区分一览

上海岑特生物科技有限公司
12 年
手机商铺
商家活跃:
产品热度:
- NaN
- 0
- 0
- 2
- 2
全部产品
- 查看全部分类
- PCR检测试剂盒
- 快速检测试剂盒/检测卡
- ELISA试剂盒
- 人类Elisa试剂盒
- 大鼠Elisa试剂盒
- 小鼠Elisa试剂盒
- 仓鼠Elisa试剂盒
- 马类Elisa试剂盒
- 兔类Elisa试剂盒
- 猪类Elisa试剂盒
- 植物Elisa试剂盒
- 鱼类Elisa试剂盒
- 猴子Elisa试剂盒
- 牛类Elisa试剂盒
- 豚鼠Elisa试剂盒
- 犬类Elisa试剂盒
- 鸭类Elisa试剂盒
- 鸡类Elisa试剂盒
- 羊类Elisa试剂盒
- 代测ELISA试剂盒
- 进口/国产ELISA试剂盒
- ELISA检测试剂盒-厂家
- ELISA试剂盒说明书
- ELISA检测试剂盒价格
- 最新试剂盒系列Omega
- 金标测试盒
- 水质检测试剂盒
- 最新检测试剂盒
- 标准品/对照品
- 标准品新品推荐
- 进口品牌标准品
- 进口标准品对照品
- 抗体
- 标记二抗
- 结构蛋白抗体
- 生化试剂
- 生化试剂厂家
- 生化试剂价格
- Roche
- Epicentre
- 进口品牌生化试剂
- 血清
- 染色液
- 免疫组化及实验试剂
- 培养基
- 耗材
- 季铵盐阳离子
- 凝胶系列
- 微生物细菌类
- 细胞株
- 电泳类
- 溶液
- 质粒载体